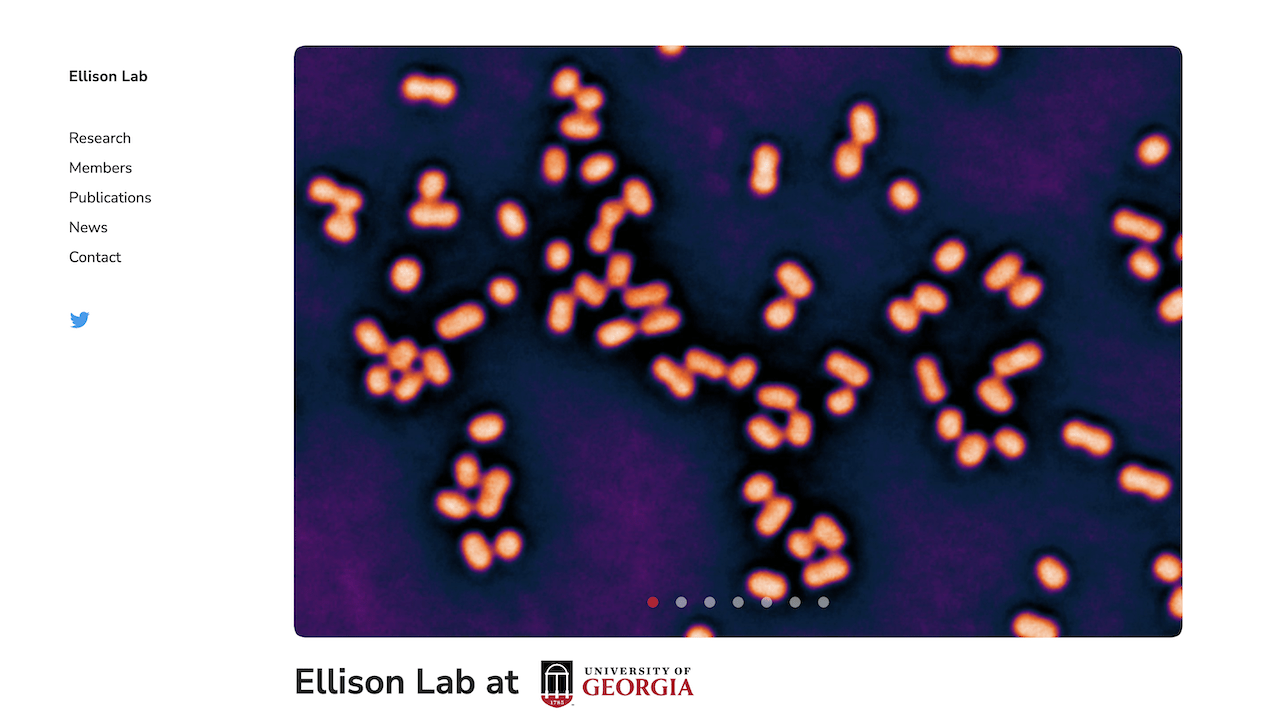

Work
Showcases some of my favorite projects.
Godfrey Design-Build
WordPress development
Designed by Leland Creative Marketing
Graduate Program in Bacteriology
Harvard University
Design & development
Official Institutions
State Street
Front-end development
Designed by MK3 Creative
The Next Alternative
State Street
Front-end development
Designed by MK3 Creative
Alumni Weekend
Oxford University
Created by Torchbox
Part of the development team